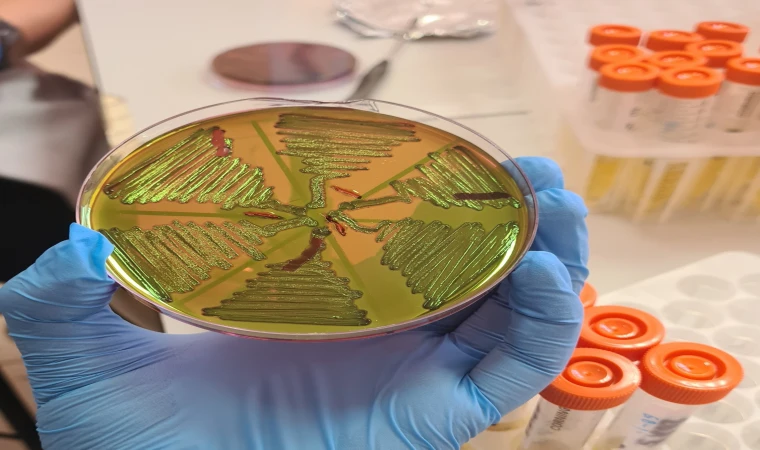
"Çiğ Süt Tüketimi, İdrar Yolu Enfeksiyonları Riskini Artırıyor"

"Çiğ Süt Tüketimi, İdrar Yolu Enfeksiyonları Riskini Artırıyor"
Çiğ süt, idrar yolu enfeksiyonlarına zemin hazırlayabilirİnönü Üniversitesi Fen-Edebiyat Fakültesi Biyoteknoloji Anabilim Dalı tarafından yürütülen bir çalışma, çiğ sütün içinde görünmez bir bakteri ekosisteminin bulunduğunu ve bu bakterilerin özellikle kadınlar, yaşlılar ve bağışıklığı zayıf kişiler için risk oluşturduğunu ortaya koydu.
Çiğ Sütte Gizli Tehlike: İdrar Yolu Enfeksiyonlarına Kapı Açıyor
İnönü Üniversitesi Fen-Edebiyat Fakültesi Biyoteknoloji Anabilim Dalı tarafından yürütülen bir araştırma, çiğ sütlerde gizlenen bakteriyel ekosistemi ortaya koydu. Araştırmaya göre, süt aracılığıyla vücuda giren bazı bakteriler sessizce üriner sisteme ulaşarak enfeksiyonlara yol açabiliyor.
Malatya kırsalından alınan 122 çiğ süt örneği üzerinde yapılan incelemelerde, bazı bakterilerin özellikle kadınlar, yaşlılar ve bağışıklığı zayıf kişiler için sağlık riski oluşturduğu belirlendi. Bilimsel Araştırma Projeleri (BAP) Birimi tarafından desteklenen “Çiğ Süt Örneklerinde Escherichia coli Prevalansının ve Üropatojenik E. coli (UPEC) Virülans Genlerinin Araştırılması” çalışması, bölgedeki sütlerde E. coli bakterisinin yüksek oranda bulunduğunu gösterdi.
Araştırmanın yürütücüsü Doç. Dr. Seval Cing Yıldırım, “Çiğ sütle ilgili bildiklerimizi önemli ölçüde değiştirecek veriler elde ettik. Topladığımız süt örneklerindeki E. coli izolatlarının büyük kısmı, idrar yolu enfeksiyonlarına neden olabilen UPEC suşlarının genetik özelliklerini taşıyor. Özellikle ‘fimA’ ve ‘agn43’ genleri neredeyse tüm izolatlarda pozitif çıktı. Bu genler, bakterilere idrar yollarına tutunma, biyofilm oluşturma ve bağışıklıktan kaçma yeteneği kazandırıyor” dedi.
Doç. Dr. Yıldırım, çiğ sütün yalnızca dışkı bulaşıyla kirlenmiş bir ürün olmadığını vurgulayarak, “Çiğ süt, hastalık yapma potansiyeli yüksek bakteriler için bir taşıyıcı ortam olabilir. Bu bakteriler sessizce üriner sisteme ulaşarak enfeksiyon oluşturabilir. Özellikle kadınlar, yaşlı bireyler ve bağışıklığı zayıf kişiler için risk artıyor” ifadelerini kullandı.
Araştırma, Türkiye’deki gıda güvenliği politikalarına da dikkat çekiyor. Doç. Dr. Yıldırım, “Mevcut denetim sistemleri hâlâ ‘bakteri var mı yok mu?’ yaklaşımıyla işliyor. Oysa verilerimiz, moleküler patojenite analizlerinin ve antimikrobiyal direnç taramalarının rutin gıda kontrol süreçlerine entegre edilmesi gerektiğini gösteriyor. Ayrıca izolatların tümü sefalotin antibiyotiğine dirençli ve çoklu antibiyotik direnci taşıyor. Bu, çiftlikten sofraya uzanan bir direnç zincirinin varlığını ortaya koyuyor” dedi.
Isıl işlemin bakteriler üzerindeki etkisine de değinen Doç. Dr. Yıldırım, “Pastörizasyon ve kaynatma büyük ölçüde etkili, ancak sağımdan depolama, taşımadan işleme ve satışa kadar uzanan hijyen zinciri doğru işletilmezse risk tamamen ortadan kalkmaz. Özellikle çiğ sütten yapılan peynirlerde kısa süreli ve yetersiz ısıl işlemler, dirençli bakterileri tamamen yok etmeyebilir. Amacımız korku yaratmak değil, bilimsel kanıtlarla desteklenen farkındalık oluşturmak. Uygun ısıl işlem ve hijyenle süt ve süt ürünleri güvenle tüketilebilir” dedi.
Araştırmada yer alan İnönü Üniversitesi yüksek lisans öğrencisi Aynur Akan, 122 çiğ süt örneğinin 6 aylık bir süreçte toplandığını ve çalışmaların bir kısmının Sinop Üniversitesi işbirliğiyle yürütüldüğünü belirtti.
Videolar için YouTube kanalımıza abone olmayı unutmayın!
BUNLARA DA BAKABİLİRSİNİZ
- 0SEVDİM
- 0ALKIŞ
- 0KOMİK
- 0İNANILMAZ
- 0ÜZGÜN
- 0KIZGIN


Yorum Yazın
E-posta hesabınız sitede yayımlanmayacaktır. Gerekli alanlar * ile işaretlenmişdir.